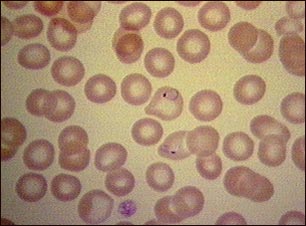
Malaria, vista microsc&oacute;pica de par&aacute;sitos celulares

![]() | ![]() | ![]() |
Malaria, vista microscópica de parásitos celulares
La malaria es una enfermedad producida por parásitos que acarrean los mosquitos. Una vez presente en el torrente sanguíneo, el parásito se aloja en los glóbulos rojos. Esta fotografía muestra parásitos de malaria teñidos de morado dentro de los glóbulos rojos.
Actualizado: 6/20/2007
